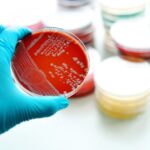

How can we protect babies from RSV infection?

RSV infection
RSV (Respiratory Syncytial Virus) is an infection that can lead to lower respiratory tract infections, such as bronchiolitis and pneumonia, particularly in infants, and may result in hospitalization. Premature infants, those with chronic lung disease, congenital heart disease, or immune system problems are at higher risk for RSV infection.
The initial signs of RSV infection in infants may include a runny nose and decreased appetite, with coughing starting within 1-3 days; fever, wheezing, and respiratory distress may develop.
Preventive antibodies for RSV are used during the winter season for at-risk infants. For years, a short-acting antibody called Palivizumab has been administered monthly from October to March to at-risk infants.
How does RSV infection progress in adults?
In adults, RSV usually causes milder upper respiratory symptoms; however, it can be severe in those with chronic diseases and older individuals. Additionally, RSV can exacerbate chronic conditions such as chronic lung disease, asthma, or heart failure.
To prevent infection, hand hygiene, avoiding contact with sick individuals, covering the mouth and nose when coughing or sneezing, and cleaning surfaces are important.
The new recommendations from the American Academy of Pediatrics on preventing RSV infection in 2025 include:
1. Use of a maternal RSV vaccine (Pfizer’s Abrysvo):
Vaccination during the 32nd to 36th week of pregnancy transfers antibodies from mother to baby, providing protection.
2. Administration of long-acting monoclonal antibodies (such as nirsevimab or clesrovimab) for newborns:
For infants born between October and March, the administration of long-acting RSV antibodies (nirsevimab) preferably in the first weeks at the birth hospital can protect the baby from infection.
The antibody treatment for infants or maternal vaccination recommended by the American Academy of Pediatrics does not interfere with other routine childhood vaccinations and can be administered simultaneously.
3. Administration of RSV vaccines is also recommended for individuals aged 75 and older and for those aged 60-74 who are at high risk for RSV.
What is the effectiveness of the maternal RSV vaccine?
Studies show that vaccinating mothers during the 32nd to 36th week of pregnancy reduces severe lower respiratory tract illness related to RSV by 80% and RSV-related hospitalizations by 55% in their babies during the first 6 months after birth. The effect is most pronounced in the first 3 months after birth, with protection decreasing as antibody levels drop after the 6th month.
What is the effectiveness of long-acting antibodies in infants?
Studies show that in infants treated with a single dose of nirsevimab, symptomatic RSV infection decreases by 70% during the first RSV season, and RSV-related hospitalizations decrease by 80%. Protection lasts about 5 months, covering the entire RSV season. Similar levels of protection have been shown in high-risk premature infants or those with chronic illnesses.
World Health Organization recommendations regarding RSV:
In its Strategic Advisory Group of Experts (SAGE) meeting in September 2024, the World Health Organization recommended the implementation of passive immunity, i.e., vaccination, for the prevention of severe lower respiratory tract infection due to respiratory syncytial virus (RSV) in all countries during early infancy.
RSV vaccines (Arexvy®, Abrysvo®, mResvia®) and monoclonal antibodies (Beyfortus®) that have been approved in the US and Europe have not yet received authorization in Turkey.